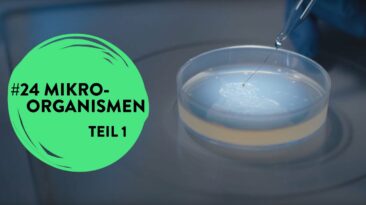

1/6 Evolution – Analogie und Homologie Säugetiere, Vögel und Reptilien haben sich unabhängig an das Leben im Wasser angepasst, ihr Körperbau weist...
Schlagwort: Naturkunde
Mythos Schlangen | Beats & Bones im Museum für Naturkunde Berlin
Sie zischen und züngeln – und haben ein ziemlich schlechtes Image. Vor Schlangen fürchten wir uns nach Spinnen am meisten. Und dabei sind sie so...
Wie Ausstellungen entstehen | Beats & Bones im Museum für Naturkunde Berlin
Wir staunen, entdecken und lernen am besten noch etwas was dazu: So eine Ausstellung kann uns schwer begeistern oder aber auch zu Tode langweilen...
School’s out!? #28: Saurier in Mitteldeutschland I Video-Podcast des Naturkundemuseums Leipzig
Naturkundemuseen und Dinosaurier gehören für viele einfach zusammen. Auch wir haben seit letztem Jahr endlich Dinos in unserer Sammlung! Gemeinsam...
Molluske des Jahres 2021 in der Senckenberg Forschungssammlung
Senckenbergs Sammlungen noch lebender sowie fossiler Tiere und Pflanzen aus aller Welt gehören mit rund 40 Millionen Zähleinheiten zu den größten...
School’s out!? #27: Herman H. ter Meer I Video-Podcast des Naturkundemuseums Leipzig
Was wäre das Naturkundemuseum Leipzig nur ohne die Dermoplastiken von Herman Heinrich ter Meer – dem Wegbereiter der modernen Präparationskunst...
School’s out!? #26: Besondere Sinne der Vögel I Video-Podcast des Naturkundemuseums Leipzig
In Folge 26 des Video-Podcasts “School’s out” schauen Direktor Dr. Ronny Maik Leder und Museumspädagogin Monika Hegenberg in der...
Von der Kaffeeforschung zur Kaffeeausstellung | Online-Führung im Naturkundemuseum Karlsruhe
Kaffeewissenschaftlerin Sara Marquart erzählt im Gespräch mit Dr. Constanze Hampp Interessantes über chemische Prozesse und Technologien der...
School’s out!? #25: Mikroorganismen 2 I Video-Podcast des Naturkundemuseums Leipzig
Weiter geht’s mit unseren “Winzigen Wundertüten”! Im zweiten Teil der Doppelfolge zum Thema Mikroorganismen ist neben Dr. Denny...
Mikrofossilien | Science Talks aus dem Naturhistorischen Museum Wien
Fossilien sind weithin bekannt – aber kennt ihr auch die allerkleinsten Fossilien, die Mikrofossilien? Kuratorin Anna Weinmann spricht heute im...
Wildes Afrika – Online Führung im Naturkundemuseum Karlsruhe
Stefanie Monninger gibt Einblicke in die verschiedenen Lebensräume Afrikas und die dort lebenden Tiere – denn es gibt in Afrika noch viel mehr als...
Das Kükengehege im Natiurhistorischen Museum Fribourg
museumTV bringt die Ausstellung Einfach Küken zu euch nach Hause! Entdeckt jeden Montag, Mittwoch und Freitag eine neue Folge der neuen Sendung...
School’s out!? #24: Mikroorganismen 1 I Video-Podcast des Naturkundemuseums Leipzig
Mikroorganismen sind winzige Wundertüten! Wo sie überall zu finden sind, was sie alles können und mit welchen Superlativen sie sich umgeben, erklären...
Biokonserve Bernstein | Beats & Bones live im Museum für Naturkunde Berlin
Bernstein ist wie ein Fernglas, mit dem wir tief in die Vergangenheit blicken können. Welche Funde sich in ihm verstecken und was sie über die Erde...
School’s out!? #23: Eduard F. Poeppig – Fortsetzung I Video-Podcast Naturkundemuseum Leipzig
In Part II der Doppelfolge über den Naturforscher Eduard Friedrich Poeppig dreht sich alles um Poeppigs Erbe. Direktor Dr. Ronny Maik Leder besucht...
School’s out!? #22: Eduard F. Poeppig – Sachsens Humboldt I Video-Podcast Naturkundemuseum Leipzig
In Part I der Doppelfolge über Eduard Friedrich Poeppig dreht sich alles um Poeppigs Reisen. Museumsmitarbeiterin Henriette Joseph erklärt, in...
Nachhaltiger Ausstellungsbau im Naturhistorischen Museum Basel
Schon seit Jahren achtet das Naturhistorische Museum Basel darauf, beim Bau seiner Ausstellungen Materialien und Bauten wiederzuverwenden. Für ERDE...
School’s out!? #21: Den Ozeanen auf den Grund gegangen I Video-Podcast des Naturkundemuseums Leipzig
In Folge 21 des Video-Podcasts “School’s out” des Naturkundemuseums Leipzig tauchen wir erneut ab, um den Ozeanen auf den Grund zu...